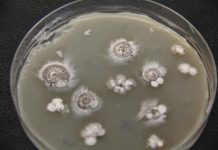
Research: Scientists find potential disease-fighting ‘warheads’ hidden in bacteria —

Research: Scientists find potential disease-fighting ‘warheads’ hidden in bacteria —
Bacteria found in soil may harbor a potential game-changer for drug design. A new study by Scripps Research, published today in Nature Communications,...
Research: Rising sea temperatures threaten survival of juvenile albatross —
Ecologists from Woods Hole Oceanographic Institution in the US and the French National Center for Scientific Research (CNRS) studied a population of black-browed...
Research: Are smarter animals are bigger troublemakers? —
You have probably encountered a raccoon raiding the trash in your neighborhood, seen a rat scurrying through the subway or tried to shoo...
Research: As an apex predator, the crocodile’s mode of attack — its mouth —...
The mouth of today's crocodilians inspires fear and awe, with their wide gape and the greatest known bite force in the vertebrate animal...
Researchers Found New Evidence About Water’s Presence on Moon
Researchers led by Masahiro Kayama of Tohoku University's Frontier Research Institute for Interdisciplinary Sciences, has discovered a mineral known as moganite in a lunar...
Report: Lowest tides in years expose Island seashore
Extremely low tides have made their way to west coast shorelines, leading to warnings for boaters and excitement from local beachcombers.
"The tides out and...
Giant supermassive black hole is captured ‘eating’ a star for first time ever
A “monster” black hole gradually eating a helpless star millions of light years from Earth has been tracked by scientists.
An international team of researchers...
Stephen Hawking’s words reach out to black hole
After Stephen Hawking's memorial service in London, the European Space Agency transmitted the physicist's words in the direction of the nearest black hole to...
Research: But increases in atmospheric carbon dioxide levels could affect stability and potential for...
Large parts of the massive East Antarctic Ice Sheet did not retreat significantly during a time when atmospheric carbon dioxide concentrations were similar...
Research: Simple chemical process that may have led to the origin of life on...
Research led by Kuhan Chandru and Jim Cleaves from the Earth-Life Science Institute at Tokyo Institute of Technology, Japan, has shown that reactions...
Top News
Hey ISIS, You Suck: Local Muslims Post Anti-ISIS Billboard
A new billboard on Manchester Road in Missouri reads, "HEY ISIS, YOU SUCK!!! From: #ActualMuslims."
A group of Muslim-Americans have put up a blunt billboard...